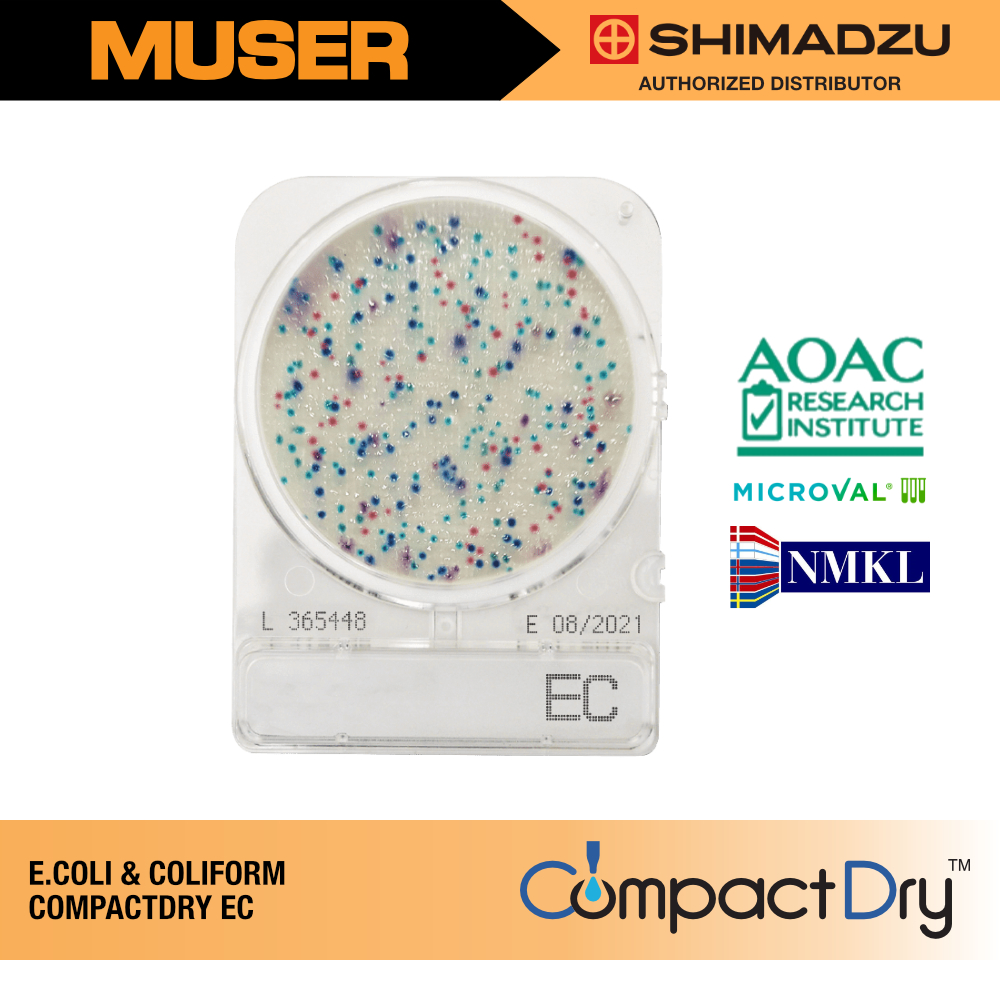

Shimadzu Diagnostics 54052 | Compact Dry EC
Simple and Easy Dry Medium for Microbial Count: E. coli and Coliforms
Conventional procedure for microbial count is complicated and time-consuming. Compact Dry is good solution for anyone to perform microbial count easily. Additionally, switching from conventional plate to Compact Dry reduces medical laboratory wastes significantly, thus helping to preserve our valuable and non-renewable resources.
| Code | Form | Package | Storage |
| 54052 | Dried | 240 Plates 1400 Plates | RT |
Compact Dry is ready to use and portable plate containing dried sheet medium. Detach necessary number of plate from a set of four by bending up and down while pressing the lid. It is available for solid food staff (homogenize with buffer solution), water or liquid sample and swab test.Drop 1 mL of specimen in the middle of dry sheet of Compact Dry (except Compact Dry SL). Inoculated sample diffuses automatically and evenly into the plate (dried sheet medium is transforming to gel form).Specimen should be diluted by buffer solution to the level of concentration of less than 300 cfu/plate. If bacteria more than 104 cfu were inoculated on a plate, no colonies are formed, and no colored colonies eventually are appeared on the plate but all plate sheets become seemingly colored.Put the cap again immediately after inoculation.Incubate at 35±1°C for 24±3 hours.
Interpretations
Medium contains two kinds of chromogenic enzyme substrate, Magenta-GAL and X- GLUC.
Red / Pink color for Coliforms except for E. coli while Blue / Blue purple color for E. coli are observed respectively. Combined total umber of both colonies of Red and Blue is the total number of Coliform group.
.gif)
.jpg)
.jpg)
.jpg)



